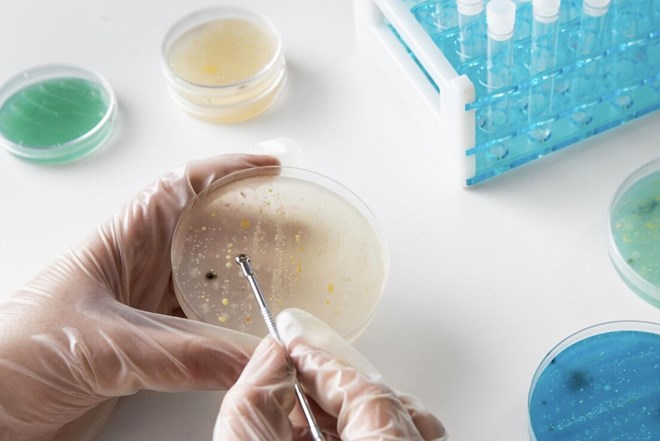

"Vi khuẩn ác mộng" tăng 70% tại Mỹ, nguy cơ kháng thuốc lan rộng
CDC cảnh báo số ca nhiễm vi khuẩn kháng thuốc tăng 70% kể từ năm 2019, gây ra thách thức y tế cộng đồng lớn và đe dọa tính mạng người bệnh.
Vi khuẩn ác mộng là gì và vì sao đáng lo ngại. Ảnh: Thùy Dương
Vi khuẩn ác mộng là gì và vì sao đáng lo ngại?
Theo báo cáo mới nhất từ Trung tâm Kiểm soát và Phòng ngừa Dịch bệnh Hoa Kỳ (CDC), số ca nhiễm trùng do "vi khuẩn ác mộng" đã tăng gần 70% trong vòng bốn năm qua. Đây là những chủng vi khuẩn kháng carbapenem, nhóm kháng sinh thường được coi là "giải pháp cuối cùng" trong điều trị các ca bệnh nặng.
Các loại vi khuẩn kháng thuốc này bao gồm Klebsiella pneumoniae và Escherichia coli, vốn không đáp ứng với điều trị bằng carbapenem. Đặc biệt, nhóm vi khuẩn sản xuất enzyme NDM (New Delhi metallo-beta-lactamase) khiến hầu hết kháng sinh mất tác dụng, khiến việc chữa trị trở nên vô cùng khó khăn.
Tiến sĩ Neha Rastogi Panda, chuyên gia bệnh truyền nhiễm tại Viện Nghiên cứu Fortis Memorial (Ấn Độ), nhận định: “Ngày càng có nhiều bệnh nhân di chuyển quốc tế và tiếp cận dịch vụ y tế ở nhiều quốc gia khác nhau, điều này góp phần thúc đẩy sự lây lan nhanh chóng của vi khuẩn kháng thuốc”.
Chỉ riêng năm 2023, Hoa Kỳ đã ghi nhận hơn 4.300 ca nhiễm vi khuẩn NDM, gấp năm lần so với những năm trước đó. Những ca bệnh này có nguy cơ tử vong cao, đặc biệt ở bệnh nhân có hệ miễn dịch yếu hoặc đang điều trị dài hạn.
Nguyên nhân gia tăng và hệ lụy
Các chuyên gia cho rằng sự lạm dụng kháng sinh trong y tế và nông nghiệp, cùng với kiểm soát nhiễm khuẩn chưa nghiêm ngặt tại bệnh viện, là nguyên nhân chính dẫn đến sự bùng phát này.
Tiến sĩ Panda nhấn mạnh: “Những người mắc bệnh mãn tính hoặc có hệ miễn dịch suy yếu sẽ đối diện với nguy cơ biến chứng nặng nề hơn khi nhiễm vi khuẩn kháng thuốc”.
Một số triệu chứng điển hình của bệnh nhiễm trùng do vi khuẩn ác mộng gồm:
Nhiễm trùng đường tiết niệu: tiểu buốt, tiểu đục.
Nhiễm trùng máu: sốt cao, huyết áp tụt, tim đập nhanh.
Viêm phổi: ho, khó thở, đau ngực.
Tiến sĩ Jonathan Smith, chuyên gia bệnh truyền nhiễm tại Đại học Yale (Hoa Kỳ), cảnh báo: “Chúng tôi đang chứng kiến những ca nhiễm trùng không đáp ứng với bất kỳ phương pháp điều trị thông thường nào. Đây thực sự là một cuộc chạy đua với thời gian để phát triển thuốc mới”.
Giải pháp phòng ngừa
Trong bối cảnh số ca nhiễm gia tăng, CDC kêu gọi cộng đồng thực hiện các biện pháp phòng ngừa cơ bản:
Chỉ sử dụng kháng sinh khi có chỉ định của bác sĩ.
Giữ vệ sinh cá nhân và môi trường sống, đặc biệt trong bệnh viện.
Theo dõi thông tin y tế công cộng, cập nhật cảnh báo dịch bệnh.
Các nhà khoa học cũng đang tập trung nghiên cứu kháng sinh thế hệ mới và các liệu pháp thay thế, song tiến độ vẫn còn chậm. Trong lúc chờ đợi, trách nhiệm cộng đồng trong việc sử dụng kháng sinh hợp lý và nâng cao ý thức phòng bệnh là biện pháp hữu hiệu nhất.
Như CDC nhấn mạnh: “Vi khuẩn ác mộng không còn là mối đe dọa xa xôi nữa. Chúng đang hiện diện và sinh sôi. Chủ động phòng ngừa chính là tuyến phòng thủ đầu tiên của chúng ta”.













